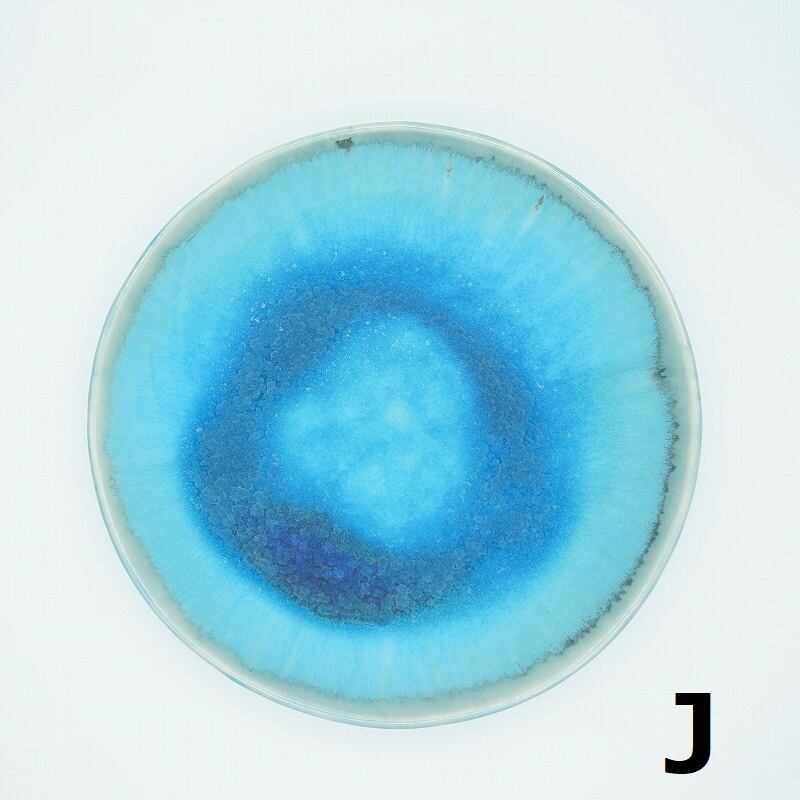

コマカアイランドブルー8寸皿【玉城焼】
南城市玉城に工房を構える【玉城焼】コマカアイランドブルーの8寸皿
「コマカアイランドブルー」という釉薬は、2018南城セレクションに選定された釉薬。
出来合いの釉薬ではなく、沖縄県産の材料を中心に、改良に改良を重ね仕上げました。
同じ釉薬を使っても、一つひとつ色の出方が違い、それぞれに味のある仕上がりになります。
8寸皿は、パーティーなどの大皿料理でもお料理が映えるサイズです。
【沖縄南城セレクション】
商品の普及と需要増を図り市内の農漁業及び商工・観光の振興に資することを目的として、南城市の地域地域資源(原材料、歴史、文化、風土、風俗、行事、技術等)を活用して開発・販売されている優良な商品を募集、審査を行い、南城市推奨品と認定する事業です。
◆サイズ(cm)径×高さ:約25.0×約3.0
※一つひとつ手づくりのため、色や形など若干の個体差があります。
◆【玉城焼】の商品はこちら
https://weeriki3.thebase.in/categories/2569345
◆作家紹介
https://weeriki3.com/稲福哲雄/
◆複数ご購入の場合の送料について
複数ご購入の場合、送料をまとめることができる場合があります。
詳しくは↓こちらをご覧ください。
https://weeriki3.thebase.in/blog/2019/10/13/172246/
◆クレジットカード決済が不安、購入の仕方がよくわからないなどお困りのことがありましたら、担当者と相談しながら購入できる方法もありますのでご利用ください。
下記のお問い合わせフォーム、またはLINEでご連絡いただくと担当者より返信させていただきますので、安心して商品をご購入頂けます。
お電話番号または、メールアドレスを入力ください。
連絡フォームはこちら↓
https://weeriki3.com/advice-form/
LINEでのご連絡はこちら↓
https://lin.ee/Wnc0cEw
¥4,180